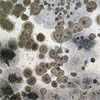

Garden Grove Water Damage Restoration and Repair Services
Water

Regardless of the cause, quick and effective water removal is crucial in preventing additional damage to property. Thoroughly drying the structure can prevent mold and mildew, as well as rust and corrosion damage to machinery, equipment and appliances. Our team will extract water and dry out the structure as well as contents using special extraction equipment, air movers, and dehumidification equipment.
Fire

Experiencing a fire at your home, school or business can be a devastating event. We understand the importance of your property and belongings and will restore items that are valuable to you. In addition to full reconstruction services, we provide for deodorization, boarding of windows and doors, water extraction, moving services and temporary storage. We will also take care of cleaning draperies, furniture and carpets to get you back to your pre-disaster state.
Mold
Discovering mold on your property can disrupt activity in your home or business. Kala offers various levels of remediation techniques that create negative air pressure and utilize HEPA-filtered air exchange systems.
Wind

Inclement weather causes significant damage to homes and businesses each year. At Kala we are available around the clock to help you rebuild when bad weather strikes. We provide damage assessments and quick, accurate estimates to repair property back to its original state.
Services We Offer
Water Damage Garden Grove, CA
Flood Damage Garden Grove, CA
Fire Damage Garden Grove, CA
Smoke Damage Garden Grove, CA
Water Damage Repair Garden Grove, CA
Flood Damage Repair Garden Grove, CA
Fire Damage Repair Garden Grove, CA
Smoke Damage Repair Garden Grove, CA
Water Damage Cleanup Garden Grove, CA
Flood Damage Cleanup Garden Grove, CA
Fire Damage Cleanup Garden Grove, CA
Smoke Damage Cleanup Garden Grove, CA
Water Damage Restoration Garden Grove, CA
Flood Damage Restoration Garden Grove, CA
Fire Damage Restoration Garden Grove, CA
Smoke Damage Restoration Garden Grove, CA
Water Damage Removal Garden Grove, CA
Flood Damage Removal Garden Grove, CA
Mold Damage Garden Grove, CA
Mold Damage Cleanup Garden Grove, CA
Mold Damage Removal Garden Grove, CA
Mold Damage Restoration Garden Grove, CA
24 Hour Emergency Fire Damage Cleanup Garden Grove, CA
24 Hour Emergency Water Damage Cleanup Garden Grove, CA
24 Hour Emergency Flood Damage Cleanup Garden Grove, CA
24 Hour Emergency Smoke Damage Cleanup Garden Grove, CA
-
24 Hour Emergency Service in Garden Grove, CA
-
Residential & Commercial Large Loss in Garden Grove, CA
-
Water Damage Restoration / Fire Damage Cleanup in Garden Grove, CA
-
Broken / Frozen Water Pipe Flood Damage in Garden Grove, CA
-
Wet Carpet Removal & Restoration in Garden Grove, CA
-
Direct Billing to Insurance in Garden Grove, CA
-
Water and Sewage Extraction & Clean up in Garden Grove, CA
-
Mold Remediation / Removal in Garden Grove, CA
-
Complete Structural Drying in Garden Grove, CA
-
Mold and Bacteria Testing in Garden Grove, CA
-
Complete Disinfection & Sanitization in Garden Grove, CA
-
Fire, Smoke and Soot Damage Cleaning in Garden Grove, CA
-
Water Damage Repairs in Garden Grove, CA
-
Asbestos Testing in Garden Grove, CA
-
We are Affordable, Fast, Friendly, Honest, Reliable & Ethical
CALL NOW FOR FAST SERVICE
What is loss mitigation?
Loss mitigation is your responsibility as a homeowner to minimize the extent of damage to your home or personal contents.
We accomplish our mission by continually educating our workforce and staff in the most advanced technology, management techniques and restoration skills - and by promoting personal growth in all our contractors. We constantly monitor our property owners and insurance company clients, seeking increased understanding of their special needs - always searching to enhance our service and ensure that our company remains on the leading edge of our Industry.


